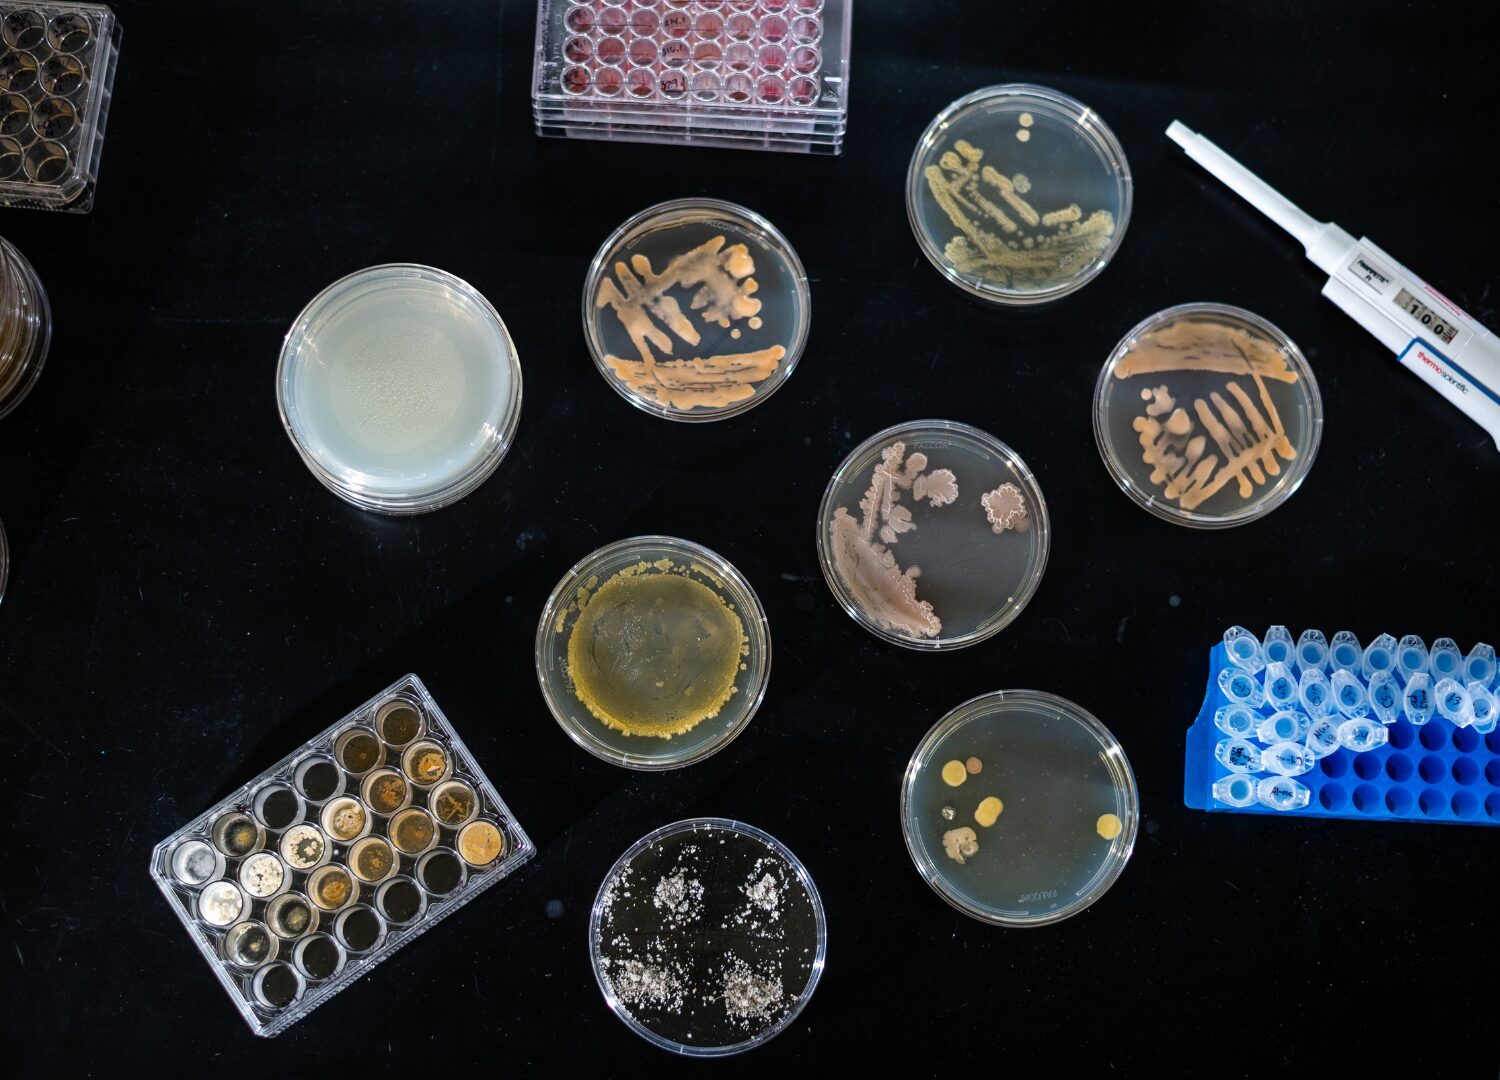

The Mimmik tile: growing architecture from bacteria
Biomason has developed a coral-inspired biocement tile for architectural applications, using biomimicry to change the way we think about building materials and their impact.

For more than two centuries, making cement has meant burning: burning limestone at furnaces that reach well over 1000° C, burning fossil fuels to sustain those temperatures, and releasing vast quantities of carbon dioxide as an unavoidable chemical byproduct. Traditional cement production accounts for roughly 8% of global CO2 emissions, and concrete is the second-most consumed material on Earth, after water.
Against this backdrop, Mimmik, a tile that grows in a mould at room temperature through the natural processes of bacteria, sounds equally absurd. Yet, it could change what we imagine architectural materials to be like. Biomason, the North Carolina company that developed Mimmik’s underlying technology, learned how nature grows one of its most robust and enduring species: coral.
Gallery
Open full width
Open full width
The principle at work is biomimicry in its most literal form: not imitating the shape of a natural structure, but replicating its natural process. Bacterial spores in the biocement are activated and then precipitate carbon and calcium to create calcium carbonate, the same chemical composition found in limestone or marble, without the need for kilns.
The company was founded in 2012 by architect Ginger Krieg Dosier, who in 2005 asked herself, “what if we could grow cement?” Years and a lot of experiments later, Dosier succeeded in answering her question positively, transitioning their production from a small lab into a company of more than 100 employees.

What distinguishes the Mimmik tile from earlier generations of low-carbon materials is the undeniable logic of its underlying chemistry. Traditional Portland cement is a calcium-silicate hydrate material whose production requires liberating carbon from limestone through intensive heating, emitting carbon dioxide as a byproduct. Biocement reverses this process, combining carbon and calcium to produce a biologically formed limestone material, meaning high heat and fossil fuels are not required, and carbon is used as a building block rather than being discarded.
The final material consists of approximately 85% granite from recycled sources as an aggregate, bound together by 15% of biologically grown limestone. After being released from the mould, the tiles cure for about 40 hours at ambient temperature. The technology is now in its third generation, and is claimed to reduce carbon dioxide emissions by at least 60% compared to conventional cement production.

The tiles are commercially available through FRONT Materials and exist in four variants: Ginger and Pepper colourways, which can be chosen in honed or polished finishes. Notable completed projects include a net-zero office at Tower Bridge Court in London, the world’s largest biocement installation to date at the Helix Lab in Kalundborg, Denmark, and sustainable office flooring in the Netherlands.
Standing back from the specifics, Biomason’s Mimmik tile is interesting not just as a product but as a demonstration of what becomes possible when the intellectual frameworks of biology and architecture converge around a genuine industrial problem. Nature will always be the world’s greatest designer, and it will always be a good idea to learn from its principles and try to apply them to our human-created and human-centred problems, finding that perhaps the solution has been there all along.